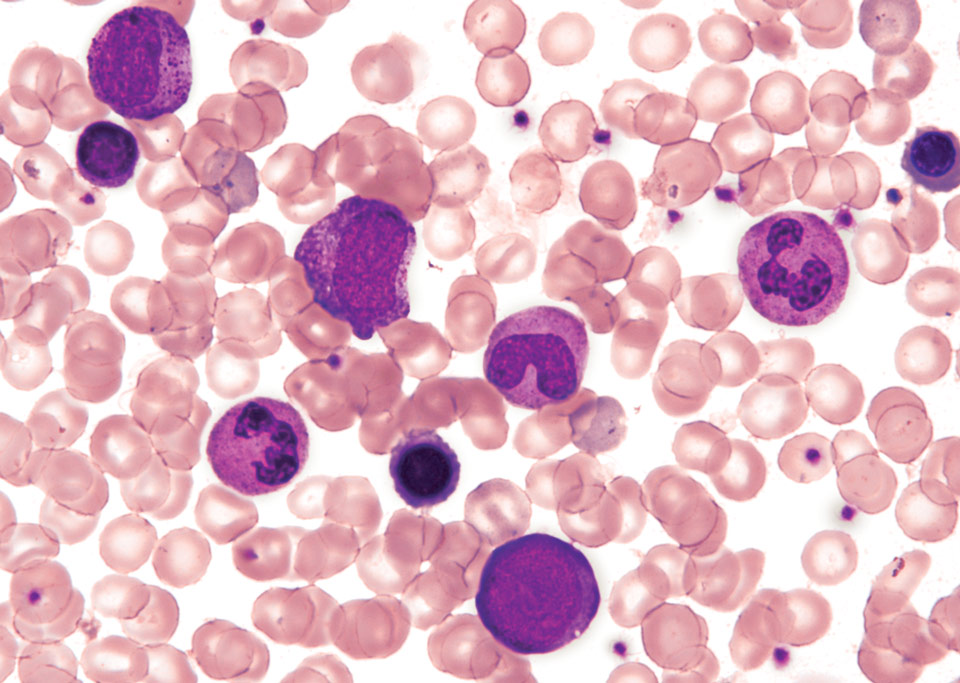

紧凑、高速、高清和高灵敏度的C-Mount摄像头
尼康的DS-Fi3是配备了590万像素CMOS图像传感器的全新高清彩色显微镜相机。其高速数据读出、优异的色彩还原和高量子效率等特性,对于各种观察方式,如明场、DIC、相差、荧光观察等都有最佳的成像效果。
Description
高清晰度成像
DS-Fi3配备了一个590万像素CMOS图像传感器,可以捕获高达2880 x 2048像素的高分辨率图像。利用最新的CMOS图像传感器和USB3.0接口进行高速数据传输,DS-Fi3即使在高分辨率成像中也能实现快速聚焦,并且在使用各种照明技术时均可实现高效的图像采集。

管状腺瘤,HE染色(物镜:CFI Plan Plan Apochromat λ 4x)
照片提供:Dr. Yasunori Ohta,Department of Pathology,
东京大学医学科学研究所IMSUT医院
高灵敏度和低噪声
DS-Fi3具有比传统型号更高的量子效率和更低的读出噪声。它允许在荧光观察中捕获具有较高信噪比的明亮的荧光图像。

乳腺癌,FISH法(物镜:CFI Plan Plan Apochromat 100x Oil)
照片提供:Hironao Kusakari, Diagnostic Pathology, 圣玛丽安娜大学医院

高速实时显示
由于CMOS图像传感器的高速数据读取和高速USB3.0数据传输,DS-Fi3能以15fps显示完整的全幅2880 x 2048像素图像的实时显示,以及1440 x 1024像素的图像的30fps实时显示,这样可以在聚焦和观察位置的选择期间平滑而流畅地显示。

The mounting board (Objective: TU Plan Fluor 5x)
出色的色彩还原效果
尼康以出色和栩栩如生的色彩还原而著称,并开发出优异的算法,用于创建更接近实际样品的图像效果。这些算法用于Digital Sight全系列所有的彩色相机。

子宫颈 Pap染色(物镜:CFI Plan Apochromat λ 60x Oil)
照片由横滨市立大学医院病理系Kazuhiro Mita提供
骨髓(物镜:CFI Plan Achromat NCG 40x)
照片由横滨市立大学医院临床实验室提供
直接连接至PC
DS-Fi3允许通过USB3.0接口直接连接到PC,以使用成像软件NIS-Elements控制摄像头并捕获图像。



